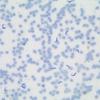

| ||||
Science Image Library - Invertebrate Photos
Science Image Library
Invertebrates
from Science Prof Online
 | ||||||
You have free access to a large collection of materials used in a college-level introductory Cell Biology Course. The Virtual Cell Biology Classroom provides a wide range of free educational resources including Power Point Lectures, Study Guides, Review Questions and Practice Test Questions.
All five photos of Eastern tiger swallowtail (Papilio glaucus) on coneflower (Echinacea purpurea).
1 & 2. Two cicada exoskeletons, southwest Michigan; 3. Eastern firefly (Photinus pyralis), southwest Michigan; 4. Honey Bee (Apis mellifera) temporary swarm; 5. Human body louse, female @ 40xTM
1 - 3. Hard scale insects on Phalaenopsis orchid; 4 & 5. Boisduval scale insect on Phalaenopsis orchid.
Page last updated 5/2014
Butterfly Photos (Click on image to enlarge.)
Scale Insect Photos (Click on image to enlarge.)
Other Insect Photos (Click on image to enlarge.)
SCIENCE PHOTOS
Other Invertebrate Photos (Click on image to enlarge.)
Protozoa Photos (Click on image to enlarge.)
1. Euglena @400xTM; 2. Formanifera @100xTM; 3. Protozoans @100xTM; 4. Trypanisoma, cause of African sleeping sickness @400xTM
1. Deer tick Ixoides @40xTM; 2. Hydra @40xTM; 3. Obelia @40xTM; 4. Trichinella spirallis in muscle tissue @ 100xTM;l 5. Tunicate larvae, closely related to vertebrates @100xTM
Didn't find what you need?
Search SPO for a Photo
SPO VIRTUAL CLASSROOMS
 | ||||||
 | ||||||
SPO is a FREE science education website. Donations are key in helping us provide this resource with fewer ads.
Please help!
(This donation link uses PayPal on a secure connection.)
The SPO Science Image Library is a continuously growing collection of copyright- free science photographs. If you use one of our free, low-res images, we just ask that you give us credit and provide a link to the SPO website (scienceprofonline.com).
To enlarge a photo below, double click on it. To save a photo to your computer, right click on it and select "Save".
For those in need of high-resolution images, we will soon be offering hi-res files of many photos in the Science Image Library. Follow us on Twitter @ScienceProfSPO to get updates on new SPO features and products. If you need a high resolution photo now, please contact us.
 | ||||
ANOTHER SPO
HOME SCIENCE PROJECT
PLANARIAN FLATWORMS
We are keeping Dugesia! These cute, cross-eyed "immortal worms" have an almost limitless ability to regenerate. Even a small piece of one can grow onto a new worm!
to meet our flatworms!
1, 2 & 3. Dugesia flatworms. Not crossed eye-spots in first two photos; 4. Planarian flatworm winter eggs of Dugesia. Viewed with dissecting microscope; 5. Full flatworm on right. Fragmented head, without body, on left.
Planarian Flatworm Dugesia Photos (Click on image to enlarge. Click here for more.)